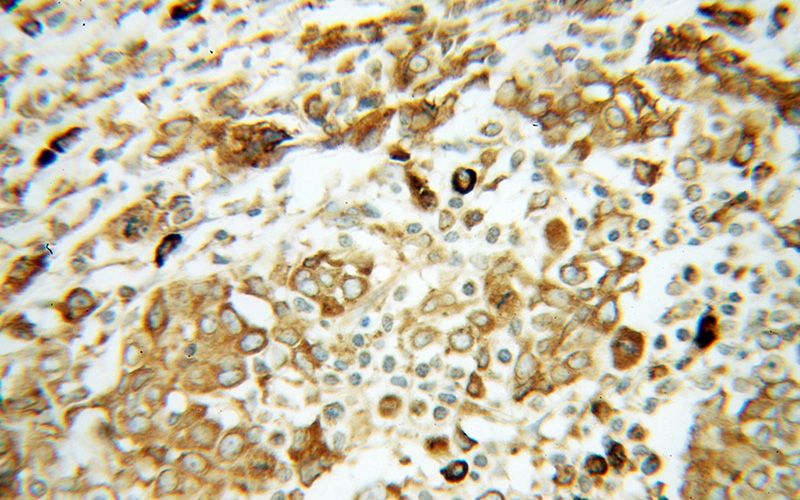
Immunohistochemical of paraffin-embedded human breast cancer using Catalog No:111223(HSP90B1 antibody) at dilution of 1:100 (under 40x lens)

-
Product Name
GRP94 antibody
- Documents
-
Description
GRP94 Rabbit Polyclonal antibody. Positive IP detected in mouse liver tissue. Positive WB detected in HeLa cells, A549 cells, HEK-293 cells, HT-1080 cells, K-562 cells, MCF7 cells, mouse heart tissue, mouse liver tissue, NIH/3T3 cells, rat liver tissue. Positive IHC detected in human breast cancer tissue, human cervical cancer tissue. Positive IF detected in A431 cells, HepG2 cells. Positive FC detected in HEK-293T cells. Observed molecular weight by Western-blot: 100 kDa
-
Tested applications
ELISA, WB, IHC, IF, FC, IP
-
Species reactivity
Human,Mouse,Rat; other species not tested.
-
Alternative names
ECGP antibody; Endoplasmin antibody; GP96 antibody; gp96 homolog antibody; GRP 94 antibody; GRP94 antibody; HSP90B1 antibody; TRA1 antibody; Tumor rejection antigen 1 antibody
- Immunogen
-
Isotype
Rabbit IgG
-
Preparation
This antibody was obtained by immunization of GRP94 recombinant protein (Accession Number: NM_003299). Purification method: Antigen affinity purified.
-
Clonality
Polyclonal
-
Formulation
PBS with 0.02% sodium azide and 50% glycerol pH 7.3.
-
Storage instructions
Store at -20℃. DO NOT ALIQUOT
-
Applications
Recommended Dilution:
WB: 1:1000-1:10000
IP: 1:500-1:5000
IHC: 1:20-1:200
IF: 1:20-1:200
-
Validations

HeLa cells were subjected to SDS PAGE followed by western blot with Catalog No:111223(HSP90B1 antibody) at dilution of 1:500

Immunohistochemical of paraffin-embedded human breast cancer using Catalog No:111223(HSP90B1 antibody) at dilution of 1:100 (under 10x lens)
Immunohistochemical of paraffin-embedded human breast cancer using Catalog No:111223(HSP90B1 antibody) at dilution of 1:100 (under 40x lens)

Immunofluorescent analysis of A431 cells, using HSP90B1 antibody Catalog No:111223 at 1:50 dilution and Rhodamine-labeled goat anti-rabbit IgG (red). Blue pseudocolor = DAPI (fluorescent DNA dye).

IP Result of anti-GRP94 (IP:Catalog No:111223, 3ug; Detection:Catalog No:111223 1:1000) with mouse liver tissue lysate 4000ug.

1X10^6 HEK-293T cells were stained with .2ug GRP94 antibody (Catalog No:111223, red) and control antibody (blue). Fixed with 90% MeOH blocked with 3% BSA (30 min). Alexa Fluor 488-congugated AffiniPure Goat Anti-Rabbit IgG(H+L) with dilution 1:1000.
-
Background
HSP90 proteins are highly conserved molecular chaperones, which normally associate with other cochaperones and play important roles in folding newly synthesized proteins or stabilizing and refolding denatured proteins after stress. HSP90B1 (GP96 or GRP94) is an endoplasmic reticulum paralogue of the cytosolic HSP90. As a major ER chaperone to mediate the UPR and a master chaperone for Toll-like receptors (TLRs), HSP90b1 chaperones peptides to MHC class I molecules of dendritic cells and other antigen-presenting cells, as well as facilitating the assembly of immunoglobulin. The protein is also involved in many other bio-processes. This antibody was generated against the C-terminal region of full-length HSP90b1.
-
References
- Zhang D, Chen C, Li Y. Cx31.1 acts as a tumour suppressor in non-small cell lung cancer (NSCLC) cell lines through inhibition of cell proliferation and metastasis. Journal of cellular and molecular medicine. 16(5):1047-59. 2012.
- Ho KY, Yeh TS, Huang HH. Upregulation of phosphorylated HSP27, PRDX2, GRP75, GRP78 and GRP94 in acquired middle ear cholesteatoma growth. International journal of molecular sciences. 14(7):14439-59. 2013.
- Kim YJ, Kim JY, Ko AR, Kang TC. Reduction in heat shock protein 90 correlates to neuronal vulnerability in the rat piriform cortex following status epilepticus. Neuroscience. 255:265-77. 2013.
- Xu D, Su C, Song X. Polychlorinated biphenyl quinone induces endoplasmic reticulum stress, unfolded protein response, and calcium release. Chemical research in toxicology. 28(6):1326-37. 2015.
- Ko AR, Kim JY, Hyun HW, Kim JE. Endoplasmic reticulum (ER) stress protein responses in relation to spatio-temporal dynamics of astroglial responses to status epilepticus in rats. Neuroscience. 307:199-214. 2015.
- Yao Z, Sun B, Hong Q. PACE4 regulates apoptosis in human prostate cancer cells via endoplasmic reticulum stress and mitochondrial signaling pathways. Drug design, development and therapy. 9:5911-23. 2015.
Related Products / Services
Please note: All products are "FOR RESEARCH USE ONLY AND ARE NOT INTENDED FOR DIAGNOSTIC OR THERAPEUTIC USE"
